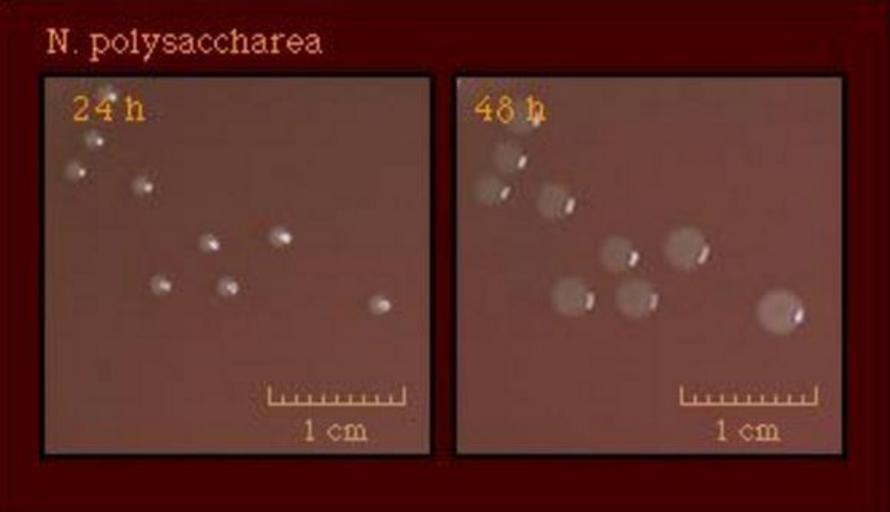

MAKE A MEME
View Large Image
| View Original: | Neisseria polysaccharea culture.jpg (579x333) | |||
| Download: | Original | Medium | Small | Thumb |
| Courtesy of: | commons.wikimedia.org | More Like This | ||
| Keywords: Neisseria polysaccharea culture.jpg en An image of the culture of Neisseria polysaccharea at 24 and then 48 hours from the Centers for Disease Control 2016-07-06 16 55 42 http //www cdc gov/std/gonorrhea/lab/npol htm Content source Division of STD Prevention National Center for HIV/AIDS Viral Hepatitis STD and TB Prevention Centers for Disease Control and Prevention last reviewed December 10 2013 United States Government other versions public domain government publication PD-USGov Neisseria Neisseria plysaccharea Bacteria colonies Centers for Disease Control and Prevention | ||||